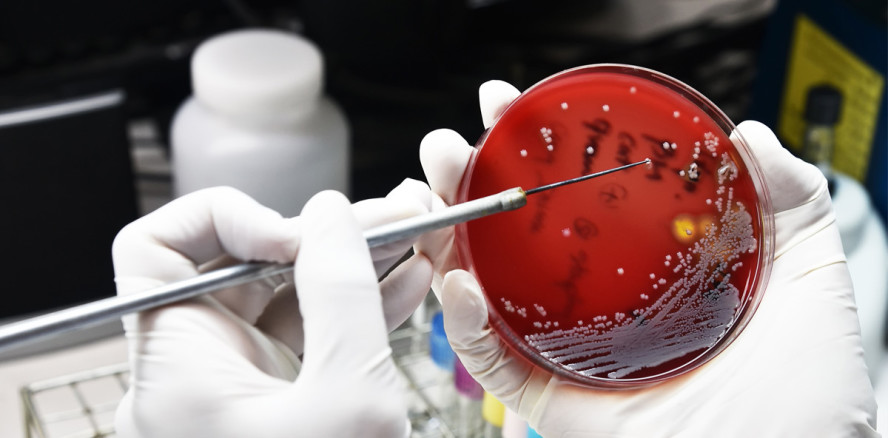
Antibiotika Awareness Woche – Kampf gegen Resistenzen

Branchenmeldungen 01.11.2017
Antibiotika Awareness Woche – Kampf gegen Resistenzen
Die Zahl der Antibiotikaresistenzen nimmt weltweit zu. Mit der internationalen Antibiotika Awareness Woche will die Weltgesundheitsorganisation (WHO) die Problematik einem breiten Publikum bewusst machen. In der Schweiz wird erstmals vom 13. bis 19. November 2017 gemeinsam mit den Akteuren aus den Bereichen Humanmedizin, Veterinärmedizin, Landwirtschaft und Umwelt über das Thema Antibiotikaresistenzen informiert und diskutiert.
Geplant sind diverse Anlässe, Publikationen und Informationsveranstaltungen. Koordiniert wird die Woche durch die Bundesämter für Gesundheit (BAG), Lebensmittelsicherheit und Veterinärwesen (BLV), Landwirtschaft (BLW) und Umwelt (BAFU). Universitäten, Experten, Branchenorganisationen, Verbände, Forschungsstätten, Gesundheitseinrichtungen, Apotheken, Konsumentenverbände und andere interessierte Akteure beteiligen sich. Zahlreiche Aktivitäten und Aktionen wie beispielsweise Symposien für Ärzte an Universitäten und Spitälern oder Referate für Laien, Ausstellungen und Schulungen an landwirtschaftlichen Hochschulen und Forschungsstätten sind bereits geplant.
Ein öffentliches Symposium von Public Health Schweiz bietet in Bern einen breiten Überblick über die aktuellen Entwicklungen im Bereich der Antibiotikaresistenzen, über die Gefahren und Risiken, aber auch über mögliche Lösungsansätze. Weiter finden spezielle Tagungen, Fachveranstaltungen und Info-Anlässe sowie Vorträge und Führungen statt.
Der übermässige und teils unsachgemässe Einsatz von Antibiotika führt dazu, dass immer mehr Bakterien gegen Antibiotika resistent werden. Der Bundesrat hat deshalb 2015 seine nationale Strategie Antibiotikaresistenzen (StAR) verabschiedet, um das Problem zunehmender Resistenzen koordiniert anzugehen.
Quelle: Bundesamt für Gesundheit